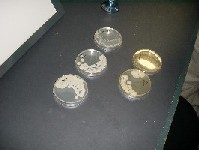

最終更新日 平成13年11月25日
















黄色ブドウ球菌を見て、ブドウという意味が分かりましたというSさん

過酸化水素水+納豆菌 → 泡がでる
過酸化水素水+乳酸菌 → 泡がでない







最終更新日 平成13年11月25日
平成13年8月18日(土)、納豆業界のカテゴリー・キラー、「挽き割り納豆の雄」として名高い、ヤマダフーズさんの茨城工場(300-0551 茨城県牛久市奥原町字塙台1753番地 電話0298-75-2111FAX 0298-30-9111)を見学してまいりました。本来であれば、土曜日の見学者対応は行っていないとのことでしたが、ヤマダフーズさんにご無理を言い、今回、ありがたいことに土曜日に対応して頂いた次第です。ヤマダフーズさんといえば、「納豆は地球を救う!」を企業のキャッチ・コピーにされておりますが、未熟な私は、まだ「納豆が救えるのは人類だけでは・・・」などと思うレベルでございますので、納豆学会のキャッチ・コピーを「納豆は人類を救う!」にしております。いずれ、私も納豆道を極め、納豆が地球を救うと確信できるようになった際には、ヤマダフーズさんにご挨拶に伺い、「納豆は地球を救う!」に変更しようと思っております。さて、今回の見学ですが、参加者はトマホークさんご一家(4名)、Sさん、ベルさん、らいきさん、稲津さん、食品総合研究所の研修生の方、そして私の計10名で、主たる目的はトマホークさんのご子息(小学一年生)の夏休み自由研究課題です。「納豆について知りたい」という、お子さまの気持ちを大切にするために、納豆学会としてもご協力しないわけにはいきません。「知りたい」「聞きたい」「調べたい」という探求心もしくは知的好奇心と言っても良いかも知れませんが、これを育てることは重要です。かの発明王・エジソンも子供の頃は、知的好奇心が強く、教師を質問ぜめにして、その質問ぶりに教師がエジソンを低能児として扱い(この教師こそが低能だと思います)、わずか三ヶ月で小学校を辞めるはめになってしまったといいます。その後は母親自身がエジソンの教師となって、彼の知的好奇心に答えた続け、才能が開花するわけですが、知的好奇心に答えること、大切にすることは、エジソンの例を持ち出すまでもなく重要です。僭越ながら、納豆学会もその精神は持っていたいと考えています。ということで、13:00にJR牛久駅東口に集合したのち、納豆工場とは思えない西洋風の茨城工場に到着して見学会の開始です。ヤマダフーズ茨城工場・事業開発室の伊藤さんにご案内頂き、まずは納豆の起源とヤマダフーズさん、茨城工場の概要説明です。
納豆の起源は、『八幡太郎義家の後三年の役』説をご説明され、発祥についても秋田県は金沢の柵であることをお話されました。「納豆発祥の石碑」については、平成12年「納豆の日」記念で行ってきました報告がございます。*「納豆発祥の石碑」報告茨城工場は、ヤマダフーズさんの首都圏でのシェア拡大の基地として、1996年に建設されたそうです。全長167mに及ぶストレートラインの三階建て工場では、大豆は三階での研磨・浸漬、2階での蒸煮、1階でその後の工程と進んでいき、50gパックで日産60万個を生産できるとのことで、大手メーカーさんの大手たるゆえんを感じます。(ちなみに秋田の本社工場の日産60万個と合わせて120万個を関東圏に出荷できる体制だそうです)工場の外観は、開放的な洋風の宮殿で、そのことを伊藤さんにお聞きしますと、「弊社社長曰く、ベルサイユ宮殿をイメージしたそうでございます」とのお答え。・・・べ、ベルサイユ宮殿でございますか。身が引き締まる思いが致します。ご説明の後、ビデオを見ることになりましたが、ここでトイレ休憩。そのトイレがちょっと変わっておりました。通常の納豆工場や食品工場では見られるトイレは、アルコールを噴霧しないと扉が開かない、手を洗う水を一定時間だせば扉が開くなどのインターロックが施されていますが、この工場の場合はなんと殺菌作用のあるエアータオルが5秒以上作動しないと扉が開かないようなインターロックになっておりました。トイレに用事がある方以外も集まり、神聖なるトイレ見学が行われたのでございます。(ちょっとアホアホ?)
トイレ見学後に約15分にわたるヤマダフーズさんの概要説明ビデオを見たのち、質疑応答。
Sさんからは、「納豆を食べるときに、パックのフタを開けますよね。このフタが邪魔で仕方ないのですが、どうにかなりませんか」とのご質問があり、私からは「パック容器は各社さんが工夫されています。ミシン目が入っていて切れるパックや、形状を変えて邪魔にならないようにしたものがあります。」とコメントさせて頂きましたが、伊藤さんからは、「弊社でも、フタを外せるようにしてある容器とそうでない容器がございます。皆さんのご意見を頂けばどちらかに統一ということはあると思いますが、それより、弊社としては環境問題に取り組もうとしており、容器の問題を何とかしようと思っています。」とのお答え。重みがあります。重厚感あふれた質疑応答を終え、いよいよ実際の工程を追いながらの見学です。トマホークさんご一家、納豆工場見学が初めてのSさん、ベルさんをはじめ、参加者の皆様は最初の工程から、目を皿のようにして見学されています。
私としては、ヤマダフーズさんの秘密兵器とも言われる、挽き割り納豆用の連続蒸煮缶を拝見できたことが一番の収穫でした。
また、リボルバー式に発酵中の納豆を入れたトレイが動く発酵室(立体自動回転室)も、品温の測定方法など参考になるところが多々ありました。納豆製造の終わりに近い工程では、納豆のラベル貼りをするのですが、最近の納豆の低価格競争で見られる4パック(3パック+1方式)は同じ機械で対応できるのかどうか、伊藤さんにお聞きしてみました。その質問に対しては、「ええ、一応5パックまで対応できます・・・」というお答え。私の思い過ごしでしょうか、伊藤さんのお答えには力無く、価格競争の厳しさを見せつけられた気がします。納豆製造工程の見学を終え、納豆に関する歴史を学ぶスペースで、納豆の容器の歴史、納豆造りの道具に関する勉強となりました。
皆さんが年表を眺めながら、お勉強されているなか、昔の納豆ラベルを食い入るように見つめて、「あ〜、このラベルほしーな」などと言っていた失礼な人間は、私でございます。失礼なばかりでは申し訳ありませんので、カテゴリー・キラーとしてのヤマダフーズさんを参加者の皆様にご紹介したところ、「ヤマダフーズさんは挽き割り納豆の美味しいメーカーとしても定評はありますが、納豆業界では奇抜な商品で挑戦する、カテゴリー・キラーとしても有名です。ウーロン茶付の納豆とかありましたよね、伊藤さん」「ええ、・・・社長が好きなんです。そういった開発が」と、ヤマダフーズさんのカテゴリー・キラーとしての活躍の源が社長殿にあることも判明致しました。すべての見学を終えたところで、お土産として「ひきわりマイルド」「徳川慶喜」を頂戴しました。ありがたいことです。
最後に、工場の前で記念撮影をして、ヤマダフーズさんの茨城工場見学終了となりました。
今回の見学は、トマホークさんのご子息様だけではなく、参加者一同、想い出深い夏の納豆工場見学となったことと思います。私も実りある見学をすることができました。ご無理をお願いしたにも関わらず、快く対応していただきました、事業開発室の伊藤さんをはじめ、ヤマダフーズ茨城工場の皆様、本当にありがとうございました。
ヤマダフーズさんの茨城工場を見学した後、つくば市学園都市に移動して、稲津さんのご厚意で「独立行政法人 食品総合研究所」内で、納豆菌などを見せていただくことになりました。食品衛生対策チームである稲津さん、研修生の方にご協力頂き、過酸化水素水に納豆菌、乳酸菌(細いタイプ)を入れた場合にどうなるかを実験して頂き、その後、大腸菌、黄色ブドウ球菌、納豆菌を顕微鏡で見せて頂いて、充実した時間を過ごすことが出来ました。
黄色ブドウ球菌を見て、ブドウという意味が分かりましたというSさん
過酸化水素水+納豆菌 → 泡がでる
過酸化水素水+乳酸菌 → 泡がでない
稲津さん、ご協力ありがとうございました。
以上で報告を終わります。参加された皆様、お疲れさまでございました。*トマホークさんから頂いた報告はこちら
トマホークさんご子息のレポート